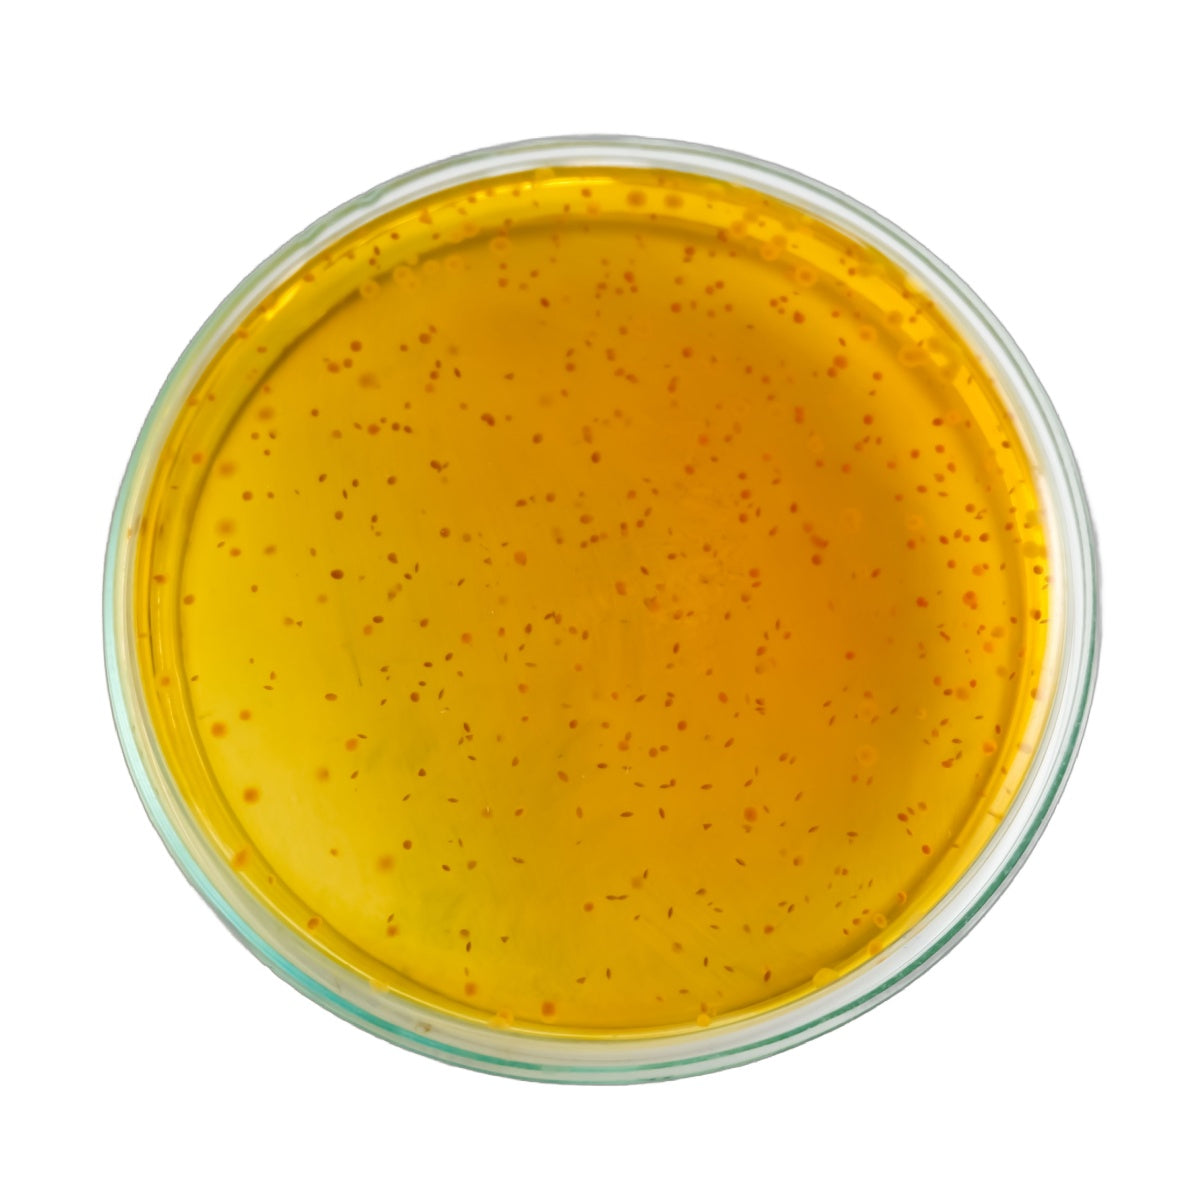

Digestion
Probiotics for Women
4.7Subscribe to Save
60-day Money Back Guarantee
*These statements have not been evaluated by the Food and Drug Administration. This product is not intended to diagnose, treat, cure, or prevent any disease.
Supports:
- Vaginal health*
- Urinary health*
- Digestive health*
- Immune system*
Product Facts:
- 18 probiotic strains
- With prebiotics
- Delayed-release capsule
- Shelf-stable CSP bottle
- Serving size of 1 capsule

Probiotics for Women
Regular price
Sale price$ 29.99 (/)
Committed to Quality
Clean Ingredients
Non-GMO
Manufactured in the USA
Gluten Free
Third Party Tested
Clean Ingredients

Cranberry Extract

D-Mannose

Lactobacillus acidophilus

Lactobacillus Plantarum

Lactobacillus paracasei

Lactobacillus Bulgaricus

Lactobacillus Brevis
Lactobacillus reuteri

Lactobacillus salivarius

Lactobacillus fermentum

Lactobacillus gasseri

Lactobacillus rhamonosus

Bifidobacterium lactis

Bifidobacterium bifidum

Bifidobacterium breve

Bifidobacterium infantis

Bifidobacterium longum

LactoSpore®

Lactobacillus Sakei

Organic Inulin (Jerusalem artichoke)

Clear Benefits
Features 18 different probiotic strains that benefit women’s digestive, vaginal and urinary health in delayed-release capsules*
Compare Products
Price
Supports
Vaginal Health* Urinary Health* Digestive Health* Immune Health*
Digestion* Gut Health* Immune System*
Digestion* Gut Health* Immune System*
Oral Health* Gum Health* Fresh breath* Gut Health* Ear Health *Throat Health* Sinus Health* Immune System*
Probiotic Strains
18 Strains
17 Strains
18 Strains
12 Strains
Probiotic CFU
20 Billion CFU
60-70 Billion CFU
30 Billion CFU
3 Billion CFU
Organic Prebiotics



